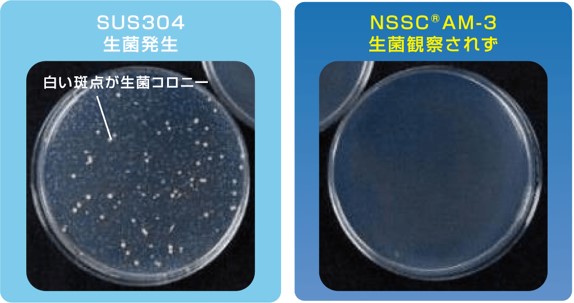

2022.01.01
日鉄ステンレス株式会社
|
NSSC®AM-3/18Cr-9Ni-3.8Cu (抗菌性・抗ウイルス性オーステナイト系ステンレス鋼板) |
抗菌効果を有する銅(Cu)を一定量添加し、鋼中にε-Cu を微細分散させ、表面からの銅
イオン溶出効果により、優れた抗菌性、抗ウイルス性(細菌及びウイルス増殖効果抑制)
を併せ持つステンレス鋼板である。

■ 特 徴
•NSSC®AM-3はステンレスの美しさ、清潔感、耐久性に抗菌性・抗ウイルス性を付与し
たステンレス鋼板である。
•抗菌性はJIS Z 2801基準(24時間後に抗菌活性値:2.0以上)を大幅に上回る速さ(4
時間)で発現、抗菌活性値は4を超える。抗ウイルス性についても、ISO 21702で試験
を実施し、SIAA 基準(24時間後に抗ウイルス活性値:2.0以上)をクリア。
•汎用ステンレス鋼板SUS304同等の加工性・耐食性も有しており、現行材からの切替、
商品の付加価値向上にも貢献。
● 抗菌即効性

● JIS Z 2801試験結果(フィルム密着法/ 大腸菌)
・24時間後の生菌数測定例
● ISO 21702:抗ウイルス性試験結果(A型インフルエンザウイルス)

■推奨用途
住宅関連、公共施設、医療・介護関連など幅広い分野に推奨。

■製品ラインナップ
・NSSC®AM シリーズとして以下ラインナップ。
・抗菌性フェライト系ステンレス鋼板NSSC®AM-1
・ 意匠性、防汚性、防カビ性を付与する抗菌性クリヤー塗装ステンレス
鋼板NS-COAT-AM


エラーが発生しました。
次のいずれかの理由が考えられます。
 カートを
カートを